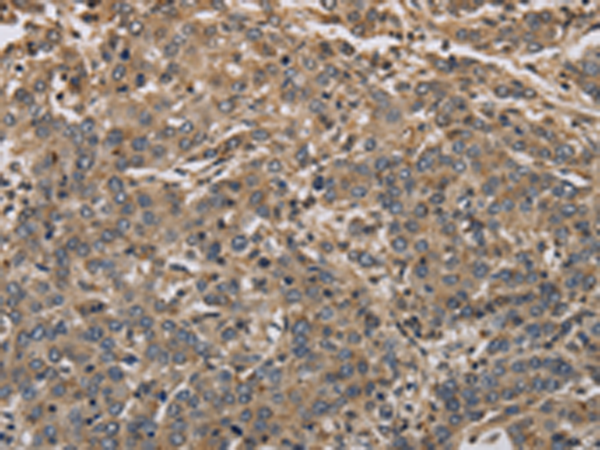

-
分类: 科研抗体货号: P04959别名: CX2; IL-17C应用: WB,IHC反应种属: Human
-
分类: 科研抗体货号: P04991别名: KCNF2; KV6.2应用: WB,IHC反应种属: Human, Mouse, Rat
-
分类: 科研抗体货号: P04956别名: MPR1; MPRI; CD222; CIMPR; M6P-R应用: WB,IHC反应种属: Human, Mouse
-
分类: 科研抗体货号: P04988别名: HAK6; KV1.7应用: WB,IHC反应种属: Human, Mouse
-
分类: 科研抗体货号: P05019别名: DLG4; HUGL; LLGL; HUGL1; HUGL-1应用: IHC反应种属: Human
-
分类: 科研抗体货号: P04987别名: GASC1; JHDM3C; JMJD2C; TDRD14C; bA146B14.1应用: WB反应种属: Human, Mouse
-
分类: 科研抗体货号: P05017别名: GPR48; BNMD17应用: IHC反应种属: Human, Mouse, Rat
-
分类: 科研抗体货号: P04985别名: IB1; JIP1; JIP-1; PRKM8IP应用: WB反应种属: Human, Mouse, Rat
-
分类: 科研抗体货号: P05016别名: pim-3应用: IHC反应种属: Human, Mouse, Rat
-
分类: 科研抗体货号: P04984别名: HJ2; SER2应用: IHC反应种属: Human

鄂公网安备42018502007531号
鄂公网安备42018502007531号

